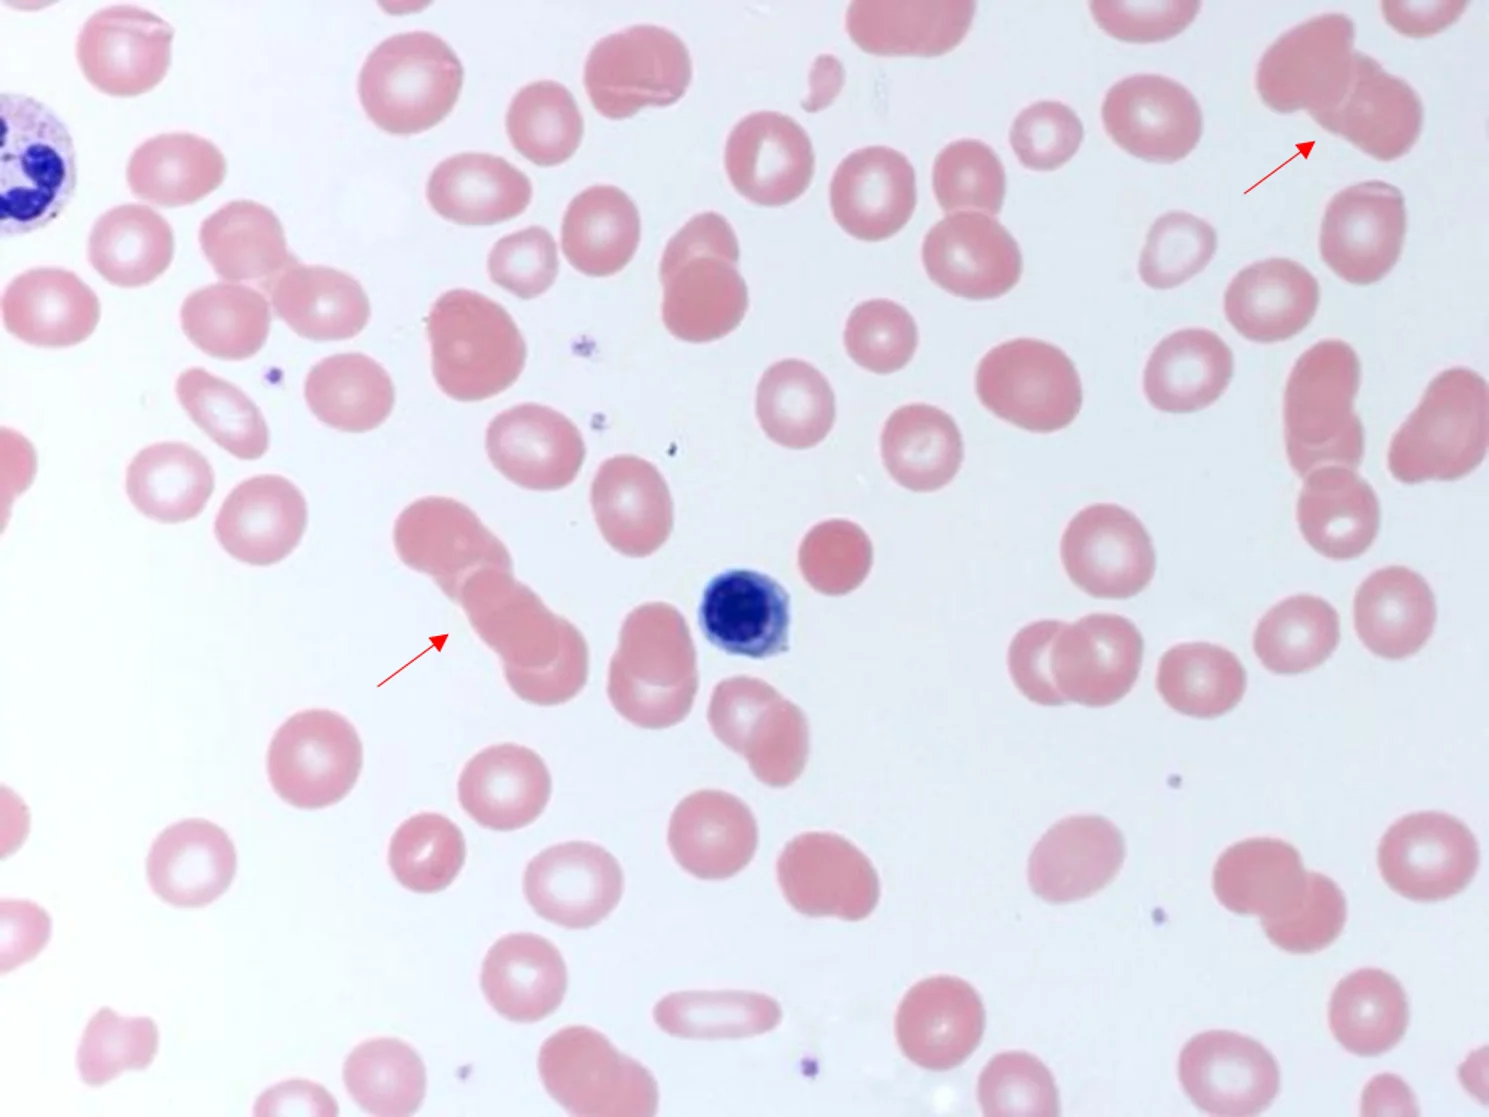

多發性骨髓瘤是本地第三常見血癌,發病原因是漿細胞癌變並增生,在骨髓不同地方沉澱形成多個病灶,導致疾病擴散。此病初期症狀為骨痛及經常疲倦,令不少患者誤以為是過勞或自然老化所致;直至病情惡化,出現腎衰竭或癌症擴散始求醫,器官已經受損,健康難再逆轉。
香港骨髓瘤學會創會主席詹楚生醫生指,多發性骨髓瘤現今尚未找到確切成因。儘管在骨髓瘤中,染色體轉移和基因突變很常見,但這些都是後天發生的,因此不是遺傳。
「已知的是,骨髓中的漿細胞有製造免疫球蛋白對抗感染的功能,譬如,感染新冠病毒和一般感冒後,健康人士會產生保護性抗體,以應付下次感染,這便是漿細胞的功能;但癌變後失去平衡,可導致漿細胞快速增生。而 TP53抑癌基因,萬一發生變異,會導致疾病迅速惡化。」
正常細胞具有固定壽命,有嚴謹的機制調節其生長和凋亡,但機制失衡時,細胞不斷增生並無法按時凋亡,便可導致癌症。根據醫管局資料,二○一二至二○二一年的多發性骨髓瘤新病例增加近五成,詹楚生醫生指主因是香港人口老化,因為多發性骨髓瘤較多出現在老人身上。
「過去醫學界認為此病是老年病,但近年我們發現有年輕化趨勢,曾見過年僅二十七歲的患者,暫時未知原因。」

⚡ 文章目錄
溶骨性病變可致骨折
既無方法預防,醫生及市民可做的,便是注意有否症狀出現,從而及早確診。詹楚生醫生表示,多發性骨髓瘤可出現「CRAB」症狀,亦即高血鈣(Hyper calcemia)、腎衰竭(Renal insufficiency)、貧血(Anemia)和骨痛(Bone lesions)。
「腰痠骨痛是最常見及最易察覺的症狀,有患者可因為溶骨性病變而骨折,甚至脊椎椎體塌陷,因此出現劇痛。」然而,多數年輕患者初時會將腰痠骨痛歸咎於肌肉繃緊或長期坐姿不正確。至於年長患者,會將其歸咎於骨質疏鬆。嚴重的,患者亦有可能出現椎旁漿細胞瘤,導致脊髓受壓,以致失禁並下肢癱瘓。因此若骨痛持續並無改善,便應懷疑是否與其他疾病有關,並盡早求醫。
值得一提的是,多發性骨髓瘤患者會分泌大量的免疫球蛋白,導致蛋白尿出現,形成泡沫尿。「除此之外,由癌細胞分泌的輕鏈蛋白積聚在腎小管時,容易凝固,令腎功能受損,最終發展為腎衰竭。」
如果市民時常感到疲倦、無精打采,並伴隨骨痛和貧血等症狀,宜及早就醫檢查。詹楚生醫生指出,由於糖尿病二型及腎炎亦可誘發蛋白尿,主診醫生通過觀察病人病情變化,判斷是否需要深入檢查。
恆常檢查或可找出端倪
恆常身體檢查無法確診多發性骨髓瘤,不過詹楚生醫生指,曾有病人於一般身體檢查時,發現紅血球沉降速率(ESR)逾 100mm/hour,但正常數值是少於 20mm/hour。
「病人並無不適,但妻子是風濕性關節炎患者,知道 ESR 超標代表 身體中有異常沉積物,因此堅持丈夫進行進一步檢查,才驚悉有早期多發性骨髓瘤。」 多發性骨髓瘤的標準檢查包括檢查血液、骨髓和影像掃描。
在驗血方面,醫生會觀察是否有單克隆的免疫球蛋白、輕鏈是否上升,以及腎功能是否下降、有否貧血或紅細胞疊連(Rouleaux Formation)等情況。此外,抽取骨髓進行檢測和進行螢光原位雜合技術(FISH),亦有助了解基因變化情況。最後,進行掃描如正電子掃描(PET-CT Scan),因為它是一種動態掃描,所以有助準確監測癌細胞的情況及位置。
嶄新藥物組合大增存活率
多發性骨髓瘤治療需經多個階段,包括誘導治療、加強治療、鞏固治療和維持治療。加強治療涉及自體骨髓移植,而鞏固治療則在自體骨髓移植後進行。因此,不適合進行移植的患者,則會由誘導治療直接進入維持治療階段。
誘導治療須使用藥物組合,包類固醇、蛋白酶體抑制劑及免疫系統調節劑,詹楚生醫生形容這個藥物組合為「三劍客」,可有效控制病情。近年亦有療程於「三劍客」之餘加入CD38單抗藥物,使治療更為全面。
「二十年前只可使用傳統化療,平均存活期僅兩年;即使有進行自體骨髓移植,存活期亦只延至三年。現今以『三劍客』加上自體骨髓移植,可有逾十至十五年存活率。再加上CD38單抗藥物的話,估計患者有可能活至二十年。」
嶄新藥物組合不僅能夠深度緩解病情,在一些病人身上,更可達到微量殘存疾病(MRD)陰性,亦即每十萬個正常細胞當中,未能找到一個癌細胞。詹楚生醫生提醒,即使此病已有完善藥物,但醫生仍須根據患者個人狀況度身定制治療方案,尤其是長者或有其他疾患的病人。
「例如類固醇較易誘發感染,同一藥量予年輕患者並無不妥,但處方予年老患者的話,就算藥量減至四分之一,他們亦未必承受得了。因此要按臨牀經驗調整至適當劑量。」
患者健康獲改善 組成病人組織互助互勉
詹楚生教授是香港骨髓瘤學會創會主席,他最初涉足血液科研究時,恰好有機會研究骨髓瘤,適逢此病有新藥推出,國際間有許多臨牀研究,亦讓他因緣際遇加入國際骨髓瘤協作組織,從此便專注於多發性骨髓瘤此一範疇。「香港骨髓瘤學會定時會收集香港各大醫院骨髓瘤病人的數據,於國際發表論文。在今年發表的研究中,其中發現適合進行骨髓移植的病人,若選擇不進行手術,其存活率明顯較低,可見即使有新藥幫助,仍然不能淘汰自體移植這個治療方法。」
為幫助病人、家屬及照顧者建立同路人網絡,詹楚生教授於二○一九年在瑪麗醫院鼓勵並協助病友成立香港骨髓瘤關愛聯盟,而這個聯盟是亞洲地區首個由骨髓瘤患者組成的組織。「昔日多發性骨髓瘤患者的身體狀況較為虛弱,經常處於危險邊緣,哪有精力組織病人團體?」然而,隨着醫療技術進步,現時多發性骨髓瘤患者的健康狀況已有極大改善,有能力團結一致,共同面對疾病帶來的挑戰。